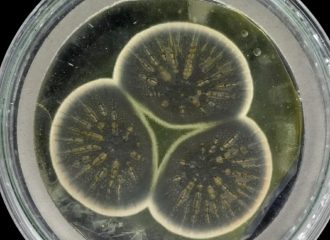

使用弗莱明留下的冷冻样本培育的青霉菌。图片来源:CABI
英国研究人员首次对亚历山大·弗莱明(Alexander Fleming)留下的青霉菌进行了基因组测序,并将其与后来的菌株做了比较。
1928 年,亚历山大·弗莱明在玛丽医院医学院(Mary's Hospital Medical School)工作期间第一次发现了抗生素——青霉素,由此一举成名。如今,这所医学院附属于帝国理工学院(Imperial College London)。青霉素由青霉菌属(Penicillium)中的一种霉菌产生,而这一霉菌却是在培养皿中意外生长起来的。
如今,来自帝国理工、国际应用生物科学中心(CABI)和牛津大学(University of Oxford)的研究人员对弗莱明最初的青霉菌菌株基因组进行了测序,使用的正是 50 年前冷冻起来的活体样本。
团队还将弗莱明的霉菌的基因组与两种美国青霉菌菌株做了比较,后者用于抗生素的工业制造。研究结果发表在《科学报告》(Scientific Reports)杂志上,该研究表明英国菌株和美国菌株使用了略有差异的方法来制造青霉素,这一发现可能暗示了工业制造的新途径。

图片来源:Pixabay
该研究团队由Timothy Barraclough教授领导,他同时任职于帝国理工的生命科学系和牛津的动物学系。他说:“我们最初打算使用亚历山大·弗莱明的霉菌展开一些不同的实验,但我们惊讶地意识到,没人对最初的青霉菌基因组进行过测序,尽管这些青霉菌在其领域中具有重要的历史意义。”
虽然弗莱明的霉菌作为青霉素的最初来源而闻名于世,但青霉素的工业制造很快用上了在美国用哈密瓜培养出的霉菌。从这些天然霉菌开始,青霉菌样本经历了人工选择,选择出能使青霉素产量更高的菌株。
研究团队使用保存在CABI培养中心的冷冻样本,重新培育了弗莱明的“初代青霉菌”,随后提取 DNA 进行测序。他们将所得到的基因组数据和先前发表的其他青霉素基因组数据做了对比,对比数据来自两支后来在美国用于工业生产的青霉菌菌株。

冷冻保存的样本。图片来源:CABI
研究人员着重分析了两类基因:一类编码用于合成青霉素的霉;另一类则调控这些酶,比如控制酶的产量。
在英国和美国菌株中,调控基因都拥有相同的遗传编码,但美国菌株拥有更多的调控基因拷贝,帮助那些菌株生产出更多的青霉素。
然而,编码青霉素制造酶的基因在两国的菌株中表现出了差异。研究人员说,这表明英美两国的野生青霉菌发生了自然演化,产生了略有差异的酶。
像青霉菌这样的霉菌会产生抗生素,来对抗细菌,同时细菌会不断演化出各种方法避开霉菌的防御手段。因此,霉菌始终处在军备竞赛中。英国和美国菌株为了适应当地的细菌,演化方向可能产生了差别。
如今,细菌演化是个大问题,因为很多细菌都对我们的抗生素产生了耐药性。尽管研究人员说,他们还不知道在英国菌株和美国菌株中,不同的酶序列对于最终形成抗生素有什么影响,他们认为这也确实为改良青霉素制造带来了可观的前景。
论文的第一作者、来自帝国理工生命科学系的Ayush Pathak说:“我们的研究可能有助于启发新的解决方案,以解决抗生素耐药性问题。青霉素的工业制造集中于产量,而人工提高产量的步骤会导致基因数量的变化。”
“但是,工业方法也许会遗漏一些优化青霉素设计的方案,而我们能够从抗生素耐药性演化的天然响应机制中找到新思路。”
翻译:阿金
审校:戚译引
引进来源:帝国理工学院

本文来自:中国数字科技馆
特别声明:本文转载仅仅是出于科普传播信息的需要,并不意味着代表本网站观点或证实其内容的真实性;如其他媒体、网站或个人从本网站转载使用,须保留本网站注明的“来源”,并自负版权等法律责任;作者如果不希望被转载或其它相关事宜,请与我们接洽。
[责任编辑:环球科学]

京公网安备11010502039775号
京公网安备11010502039775号





